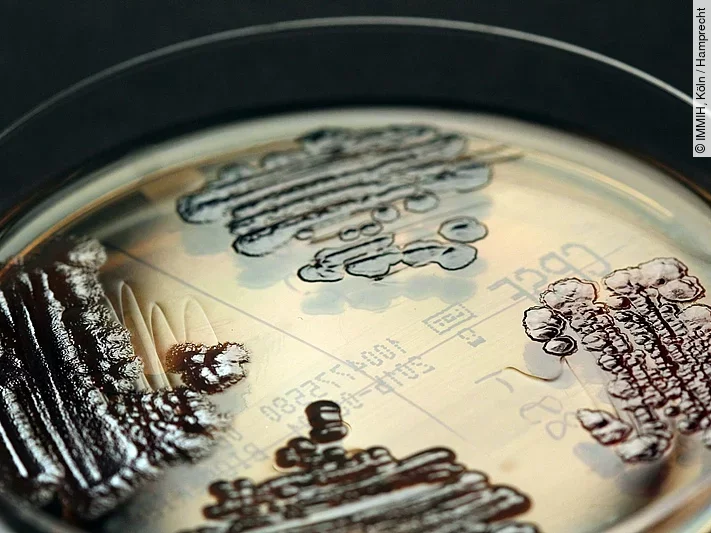
Multiresistente Keime

Im Immanuel Klinikum Bernau ist auf einer Intensivstation bei neun Patienten der multiresistente Darmkeim Klebsiella pneumoniae nachgewiesen worden. Einer der Patienten mit einer lebensbedrohlichen schweren Grunderkrankung starb. „Wir gehen davon aus, dass die Grunderkrankung die Ursache war. Die Todesursache wird aber nun untersucht“, sagte Sprecherin Jenny Jörgensen am Dienstag. Der betroffene Patient ist am Montag gestorben.
„Wir nehmen die Situation sehr ernst“
„Wir nehmen die Situation sehr ernst. Die Sicherheit unserer Patienten ist unsere wichtigste Aufgabe. Alle Patienten auf der Intensivstation und deren Angehörige wurden über das Ausbruchsgeschehen informiert. Wir sind in engem Austausch mit den Behörden“, so Geschäftsführer Andreas Linke. „Die betroffenen Patienten sind weiterhin streng isoliert und werden von eigenem ärztlichen und pflegerischen Personal betreut. Die intensiven Reinigungs- und Desinfektionsmaßnahmen und umfangreichen Testungen von Patienten sowie Geräten und Oberflächen werden kontinuierlich wiederholt“, sagte Krankenhaushygieniker Michael Zänker.
Keime sind gegen alle zugelassenen Antibiotikagruppen immun
Von den neun Patienten war bei drei Personen eine Infektion mit dem Erreger festgestellt worden. Einer der Patienten konnte demnach bereits vergangene Woche entlassen werden. Die anderen beiden Patienten wurden mit Reserveantibiotika behandelt. Nachdem beide Patienten zunächst klinisch stabil waren, starb einer der Beiden nach längerer intensivmedizinischer Behandlung. Bei sechs Personen wurde eine Besiedlung mit dem Erreger festgestellt, aber keine Infektion. Vier von ihnen wurden bereits aus der Klinik entlassen.
Klebsiella pneumoniae ist ein Keim, der beim gesunden Menschen zu den normalen Bewohnern des Magen-Darm-Trakts zählt. Anderswo, zum Beispiel in der Lunge, ist er gefährlich. Manche Klebsiella-Keime sind resistent gegen Medikamente. Am gefährlichsten sind die der Klasse 4-MRGN, eine Abkürzung für „multiresistent gramnegativ“, wie sie in Bernau nachgewiesen wurden. Sie sind gegen alle vier üblichen gegen das Bakterium zugelassenen Antibiotikagruppen immun. Dann besteht nur noch Hoffnung auf Reserve-Antibiotika.





Derzeit sind noch keine Kommentare vorhanden. Schreiben Sie den ersten Kommentar!
Jetzt einloggen